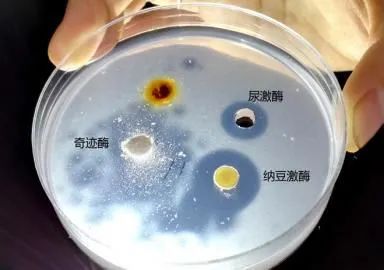

13854例,这是北京“120”一个月的心脑血管抢救病例。
据统计,2021年10月1日至11月5日一个多月时间内,北京急救中心派出的急救车用于急救的案例中,数量分别为:
· 第1位:心血管病(7956例)
· 第2位:脑血管疾病(5818例)

心脑血管问题,已成为威胁中老年人健康的头号“杀手”!

报告还指出,由于油腻饮食、吸烟酗酒、熬夜等不健康习惯,中国患有高血压、血脂异常、糖尿病和肥胖人数还在不断攀升,导致心血管病发生率越来越高、人群越来越年轻…

前段时间,办公室有位同事,上班上的好好的,突然就晕倒了。
医生说,是长时间抽烟喝酒,加上熬夜加班,导致的急性心梗,要是送医再晚一点,可能就来不及了…

心脑血管疾病,无论是心梗、脑梗、血栓、动脉硬化等,根源都是同一个:血管堵塞!

打个简单的比方,如果人是一台车,心脏就是发动机,大脑是芯片。


这些脏东西如果得不到清理,就会在血管内不断堆积,形成斑块堵塞血管,直至血管被彻底堵死…下一步,就是血栓、动脉硬化、甚至梗死!

01
“天然血管清道夫”
每天吃一点 血管干净通畅









02
“血管守护神”
养护强化血管 增加生命的韧性

随着年龄的增大,血管就像水管一样
用的时间久了,也在慢慢老化
不仅容易血流不畅发生堵塞
更有可能因不堪重压,直接破裂…


山消糕中含有的高活性成分
能消洗附着在毛细血管壁上的血垢
调节胆固醇,血液粘稠度
使微血管更畅通
从而使细胞代谢的废物毒素
更轻易排出体外

细胞得到充足营养、代谢正常
没有毒素伤害
细胞寿命大大延长
人越活越年轻
远离各种“老年病”

03
资深名老中医配比
甄选优质原材 清通调三管齐下
这款控谷红曲纳豆山消糕,由资深张涌川老医师和多位国家高级营养师,历经多年潜心研发而成,谷物草本配伍,最大程度地发挥药食同源的特性。

每一种成分都有独特作用,不加蔗糖,无色素、无香精、无防腐剂,根据精湛配比,制作而成。

纳豆红曲山消糕甄选天然原料,纳豆、红曲、DHA藻油、沙棘油等,完美搭配,将心脑血管里多余的胆固醇及其他血栓油脂等溶解分离出来,并且修复和激活体内细胞,加倍呵护心脑血管健康。

在原料选择上同样精益求精!
中医选材讲究因地制宜,比如配方中的红曲米,选用的是古田红曲米的制作技艺,被列为当地的非物文化遗产!采用传统的红曲制作古法,严控原材,才做出这样优质的红曲米。

所以普通用于着色的红曲米,颜色更深,发酵更“彻底”,连米心都是红色,但他汀含量却更低
而用于山消糕的古田红曲米,会严格控制发酵时间,不会等到完全发酵,所以颜色稍浅,米心依然是白色的,这种米的他汀含量才是最高的!

正是因为对原料的极致要求,才成就了这小小一块搞点极好的食疗效果!三管齐下,轻松通血管、溶血栓——
第一步,多元化溶栓机制,强力溶解血栓。纳豆+红曲,二合一复合强效配方,“纳豆激酶”具有溶解血中纤维蛋白的作用,有效溶解血栓及隐形血栓,改善因心脏供血不足引起的头晕目眩,胸闷气短的症状。

第二步,清除血液垃圾。山消糕能促进肠胃蠕动和吸收,清理沉积在血管壁血液垃圾和脱落的斑块,强力扫除血液中的废物。
第三步,阻断合成胆固醇通道,根本预防血栓形成。红曲结合陈皮、山楂、DHA藻油等,阻断合成胆固醇通道,软化血管,防止血栓形成,预防动脉粥样硬化。

每天吃上几袋它,轻松告别各种慢性“老年病”,轻食养生,养出通畅、长寿的血管,腿脚有力精神好!

权威机构检测认证,品质效果都有保障!



写下你的想法